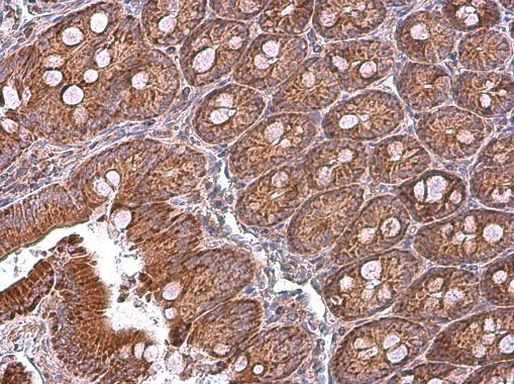
MFN1 Antibody in Immunohistochemistry (Paraffin) (IHC (P))

Search
Invitrogen
MFN1 Polyclonal Antibody
{{$productOrderCtrl.translations['antibody.pdp.commerceCard.promotion.promotions']}}
{{$productOrderCtrl.translations['antibody.pdp.commerceCard.promotion.viewpromo']}}
{{$productOrderCtrl.translations['antibody.pdp.commerceCard.promotion.promocode']}}: {{promo.promoCode}} {{promo.promoTitle}} {{promo.promoDescription}}. {{$productOrderCtrl.translations['antibody.pdp.commerceCard.promotion.learnmore']}}
产品信息
PA5-78563
种属反应
宿主/亚型
分类
类型
抗原
偶联物
形式
浓度
规格
纯化类型
保存液
内含物
保存条件
运输条件
RRID
产品详细信息
Positive Control: human kidney, mouse heart, rat kidney
Predicted Reactivity: Pig (86%), Rhesus Monkey (86%), Bovine (86%)
Store product as a concentrated solution. Centrifuge briefly prior to opening the vial.
靶标信息
Mitofusin 1 (MFN1) and the related protein MFN2 are mitochondrial membrane GTPase proteins that play a central role in mitochondrial metabolism and may be associated with obesity and/or apoptosis processes. MFN1 and MFN2 form homotypic and heterotypic complexes and coordinately regulate mitochondrial fusion and are essential for embryonic development. When ectopically expressed, MFN1 inhibits the apoptosis-associated amino-terminal conformation change in the apoptotic protein Bax but not its mitochondrial translocation, indicating that MFN1 is involved in the regulating the activation of Bax on the outer mitochondrial membrane.
仅用于科研。不用于诊断过程。未经明确授权不得转售。
篇参考文献 (0)
生物信息学
蛋白别名: DKFZp762F247; EC 3.6.5; FLJ20693; Fzo homolog; MFN1; putative mitochondrial transmembrane GTPase; MGC41806; mitochondrial transmembrane GTPase Fzo-1; mitochondrial transmembrane GTPase FZO-2; Mitochondrial transmembrane GTPase FZO1B; Mitofusin-1; putative transmembrane GTPase; similar to Drosophila fuzzy onions encoded by GenBank Accession Number U95821; Transmembrane GTPase MFN1; unnamed protein product
基因别名: 2310002F04Rik; 6330416C07Rik; D3Ertd265e; Fzo1b; hfzo1; hfzo2; HR2; MFN1; mKIAA4032
UniProt ID: (Human) Q8IWA4, (Rat) Q8R4Z9, (Mouse) Q811U4
Entrez Gene ID: (Human) 55669, (Rat) 192647, (Mouse) 67414